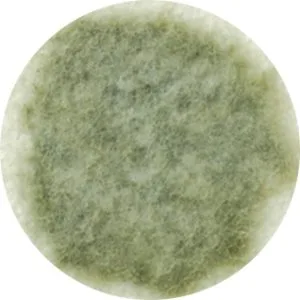
M120.e

Máy hút ẩm Mitsubishi MJ-M120TX khử mùi diệt khuẩn
8.550.000 ₫
Hết hàng
Thông tin nhanh
Câu hỏi thường gặp
Chưa có câu hỏi nào.
Mô tả chi tiết
Máy hút ẩm Mitsubishi MJ-M120TX nội địa Nhật Bản có thiết kế nhỏ gọn cùng công suất lớn, công nghệ hiện đại giúp hút ẩm tốt, diệt nấm mốc trong những ngày nồm mang lại không gian thoáng đãng an toàn. Máy hút ẩm Mitsubishi MJ-M120TX nội địa Nhật Bản giúp hút ẩm sạch sẽ, sấy khô quần áo với độ bền cao, độ ồn thấp, dễ dàng sử dụng với mọi đối tượng.
Thiết kế nhỏ gọn, hiện đại
Máy hút ẩm Mitsubishi MJ-M120TX nội địa Nhật Bản có thiết kế nhỏ gọn với màu trắng chủ đạo thích hợp với mọi thiết kế nội thất, bình đựng nước có thể tháo rời dễ dàng, hoạt động liên tục 24/7 ổn định và bền bỉ
Hút ẩm nhà cửa
Máy hút ẩm Mitsubishi MJ-M120TX nội địa Nhật Bản hút ẩm mọi ngóc ngách như dưới sàn sofa, gầm gường hay trên trần nhà khó vệ sinh trong căn nhà của bạn giúp diệt trừ nấm mốc, vi khuẩn có hại. Những giọt ứ đọng trên thành kính hay tường cũng được hút triệt để không gây khó chịu. Máy hút ẩm Mitsubishi MJ-M120TX nội địa Nhật Bản có công suất lơn hút 12 lít/ngày

Sấy khô quần áo
Máy hút ẩm Mitsubishi MJ-M120TX nội địa Nhật Bản giúp sấy khô quần áo một lượng lớn quần áo tiện lợi cho những ngày nồm khó chịu giúp cho quần áo khô nhanh chóng. Máy hút ẩm Mitsubishi MJ-M120TX nội địa Nhật Bản còn có chức năng sấy nhanh một lượng nhỏ quần áo khi bạn muốn sử dụng quần áo luôn.

Vị trí, số lượng và tình trạng giặt được phát hiện trong một phạm vi rộng và chi tiết bởi ba cảm biến (tia hồng ngoại, nhiệt độ và độ ẩm). Cửa chớp góc rộng ba chiều thổi không khí rộng và khô nhanh.Góc di chuyển của cửa chớp ngắm góc rộng 3D

- Model: MJ-M120TX
- Điện áp: 100V
- Kích thước: Chiều cao 534×Rộng 360×Sâu 210mm
- Trọng lượng: 13,5kg
Đánh giá (0)
 Máy hút ẩm Mitsubishi MJ-M120TX khử mùi diệt khuẩn
Máy hút ẩm Mitsubishi MJ-M120TX khử mùi diệt khuẩn
Câu hỏi & Giải đáp
Câu hỏi & Giải đáp
 Máy hút ẩm Mitsubishi MJ-M120TX khử mùi diệt khuẩn
Máy hút ẩm Mitsubishi MJ-M120TX khử mùi diệt khuẩn












Đánh giá
There are no reviews yet